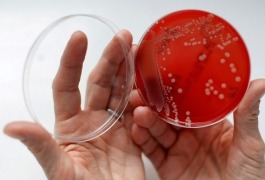

Главная
Новости стерилизации…
Новости стерилизации и дезинфекции
-
Медицинские отходы обнаружены на свалке в Республике Алтай
-
Золотистый стафилококк виновник развития волчанки
-
87 младенцев потенциально подвергнуты опасности заражения туберкулезом в госпитале Торонто.
-
Роспотребнадзор закрыл два отделения за нарушения санитарно-эпидемиологического режима
-
Нарушения санитарных норм в "Кишертской центральной районной больнице" устранены
-
Фотодинамическая терапия в лечении золотистого стафилококка
Оказывается, не нужно бежать к кварцевой лампе или глотать антибиотики, чтобы уничтожить все микробы на коже. Немецкие учёные предложили быстрый метод изведения таких опасных патогенов, как золотистый…